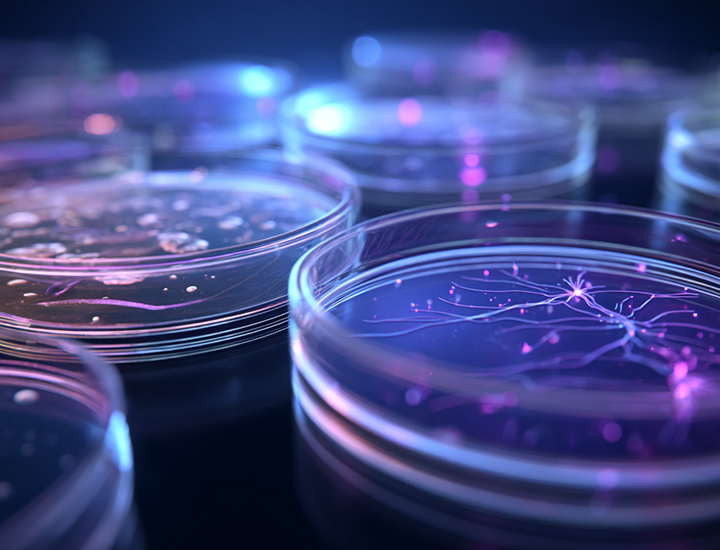

Mechanistic modeling is the center
of our solutions
of our solutions
Next-Generation Risk Assessment (NGRA)
Our expertise in Physiologically-Based Kinetics (PBK) and Quantitative Systems Toxicology (QST) models, including Quantitative Adverse Outcome Pathways (qAOP), drives the adoption of computational methods as non-animal alternatives in chemical risk assessment.
Overall, computational methods are experiencing a resurgence in chemical risk assessment and ESQlabs is at the heart of this development.
Our Services
Model Informed Drug Development
We streamline and accelerate drug development by using quantitative pharmacokinetics, efficacy, and toxicity predictions to optimize trial design and decision-making.
Next Generation Risk Assessment
We predict toxicity risks, reducing reliance on animal testing while ensuring safety and compliance.
Software Development
We integrate and develop software solutions to support modeling and simulation across various applications, contributing to the advancement of the OSP Suite.
Trainings and Education
Our online courses provide step-by-step guidance to enhance your OSP Suite skills, featuring the latest versions of PK-Sim® and MoBi®.
Our consultancy
services
services
At ESQlabs, we go beyond delivering results – we empower you to take full ownership of your processes and the solutions we deliver. Our solutions are tailored to your research needs and questions, accompanied by expert guidance to help you master mechanistic modeling and ensure regulatory compliance.
Whether you need training, consultancy, or innovative support, our team of world-class scientists is here to ensure your success in achieving your research goals.
Our commitment
to the OSP Suite
to the OSP Suite
As a proud member of the Open Systems Pharmacology (OSP) community, ESQlabs is the leading contributor to the development of the OSP Suite, including PK-Sim® and MoBi®.
We operate as a contract research organization, supporting sponsors’ mechanistic MIDD efforts and conducting R&D activities to advance the tools, methods, and software that drive innovation in the field.
Our workshops and webinars
Our team organizes and delivers a variety of workshops throughout the year, online or in person. To stay current on upcoming sessions, check our upcoming events below and follow us on LinkedIn, where we regularly share updates and announcements.